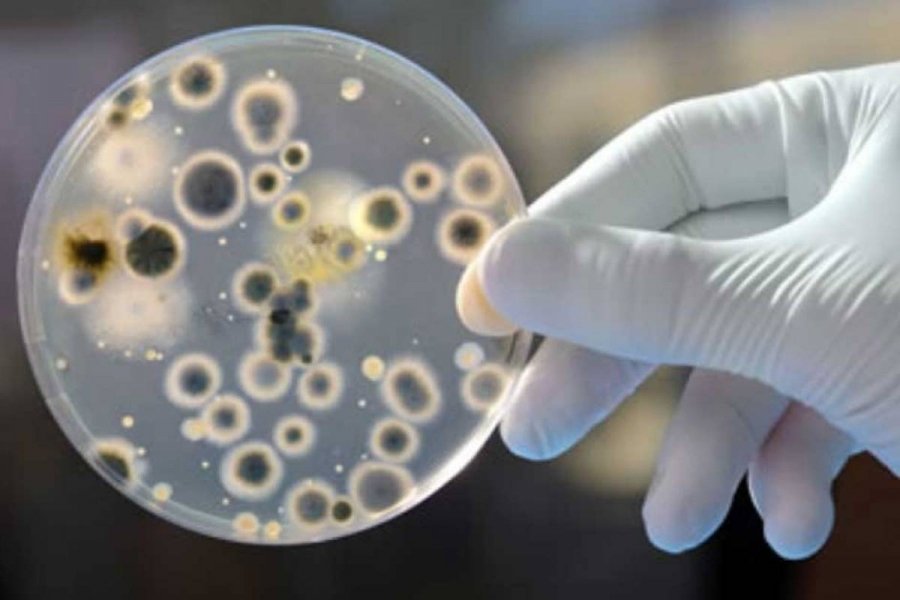

As infecções hospitalares causadas por fungos multirresistentes devem se tornar cada vez mais comuns, segundo o pesquisador do Instituto de Medicina Tropical da Universidade de São Paulo João Nóbrega de Almeida Jr. “Se existe a superbactéria, existe o superfungo também”, disse o especialista que atua também no Hospital da Clínica de São Paulo ao comparar os fungos resistentes à superbactéria KPC (Klebsiella pneumoniae carbapenemase).
Recentemente, Almeida publicou um artigo no jornal científico Transplant Infectious Disease sobre o primeiro caso de um paciente contaminado pelo fungo Lomentospora prolificans na América do Sul. O rapaz havia feito transplante de medula há cerca de um mês quando foi infectado pelo fungo e acabou morrendo em decorrência da contaminação.
Segundo o pesquisador, o fungo só é capaz de afetar pessoas com o sistema imunológico comprometido. No entanto, caso a contaminação aconteça, a letalidade é de mais de 80%. Como ainda existem poucos laboratórios preparados para identificar esse tipo de infecção, Almeida acredita que possa haver casos não registrados. “Esse fungo não deve ter em grande quantidade no ambiente, como em outros países, mas também porque os nossos laboratórios não são habilitados para fazer o diagnóstico”, afirma.
Existem, entretanto, outros fungos que apresentam uma ameaça maior por poderem infectar não só pacientes com o sistema imunológico fragilizado, mas em situação delicada de internação, como em unidades de tratamento intensivo. Esse é o caso do Cândida auris.
Surtos na América do Sul
Em março de 2017, a Agência Nacional de Vigilância Sanitária (Anvisa) divulgou um comunicado de risco para o fungo, responsável por surtos em diversas partes do mundo. Foram registradas ocorrências no Japão, na Coreia do Sul, na Índia, no Paquistão, na África do Sul, no Quênia, no Kuwait, em Israel, na Venezuela, Colômbia, no Reino Unido, nos Estados Unidos e no Canadá. O Centro de Controle e Prevenção de Doenças dos Estados Unidos tem emitido alertas para o fungo.
As ocorrências em países da América do Sul indicam, de acordo com o pesquisador, que em algum momento o Brasil terá de lidar com o Cândida auris. “A gente está se preparando com uma força-tarefa nacional com vários pesquisadores para quando chegar esse fungo no país a gente fazer o diagnóstico correto”, ressalta.
Agrotóxicos e mudanças climáticas
As infecções hospitalares por fungos têm se tornado mais comuns devido ao aumento da resistências de algumas variedades desses organismos. Segundo Almeida, há indícios que o surgimento dos fungos multirresistentes está ligado ao uso de defensivos agrícolas. “A gente acredita [que o surgimento dos fungos multirresistentes acontece] principalmente pelo uso de antifúngicos fora do ambiente hospitalar. Na agricultura, por exemplo, nas plantações, os fungos são os principais biodecompositores, vão destruir verduras, plantas”, destaca.
As mudanças climáticas também parecem ter, de acordo com o pesquisador, uma contribuição para o aparecimento de espécies que não são afetadas pela medicação existente. “O aquecimento global. As alterações climáticas vão favorecer o aparecimento de fungos que crescem em temperaturas maiores. E os fungo que crescem em temperaturas maiores são os potencialmente patogênicos, porque o nosso corpo tem temperatura de 36 graus”, acrescentou.
Apesar da expansão do problema, Almeida enfatiza que não há risco para a população em geral. São os sistemas de saúde que precisam se preparar para lidar com as novas possibilidades de infecção dentro dos hospitais.